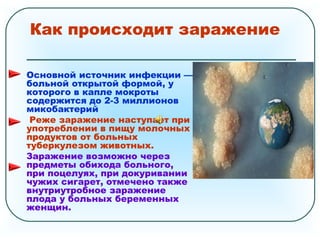
Как происходит заражение
Основной источник инфекции —
больной открытой формой, у
которого в капле мокроты
содержится до 2-3 миллионов
микобактерий
Реже заражение наступает при
употреблении в пищу молочных
продуктов от больных
туберкулезом животных.
Заражение возможно через
предметы обихода больного,
при поцелуях, при докуривании
чужих сигарет, отмечено также
внутриутробное заражение
плода у больных беременных
женщин.

Туберкулез, вызванный микобактерией, представляет собой серьезную глобальную угрозу, способствуя высокому уровню заболеваемости и смертности. Основные симптомы включают длительный кашель, слабость и кровохарканье, в то время как лечение требует комплексного подхода с использованием нескольких противотуберкулезных препаратов. Профилактика включает вакцинацию и соблюдение личной гигиены, что важно для предотвращения распространения инфекции.